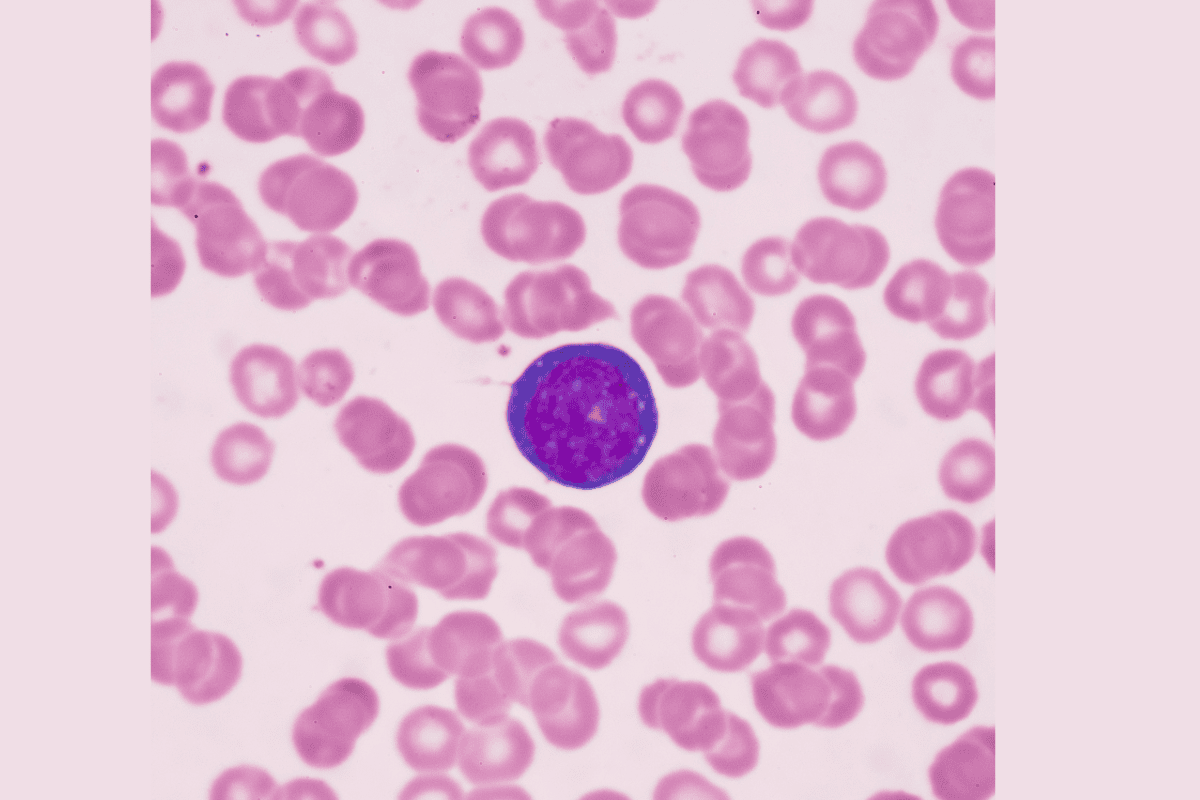

INSIGHTS | 5 min read
Neuroendocrine Tumor Lung Overview: Causes, Sypmtoms & Treatment
Dr. Vrundali KannothFriday 9th JanLearn More
INSIGHTS | 5 min read
Atypical Ductal Hyperplasia: Meaning, Risks & Treatment Guidance
Dr. Vrundali KannothFriday 9th JanLearn More
INSIGHTS | 5 min read
Understanding Neurofibromatosis Type 1 and Its Impact on Health
Dr. Vrundali KannothFriday 9th JanLearn More
INSIGHTS | 5 min read
Prostate Specific Antigen Explained: A Simple Guide to PSA Levels
Dr. Vrundali KannothWednesday 7th JanLearn More
INSIGHTS | 5 min read
Multiple Endocrine Neoplasia - Symptoms, Types and Treatment
Dr. Vrundali KannothWednesday 7th JanLearn More
INSIGHTS | 5 min read


